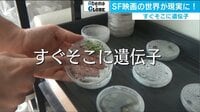
Abema×GLOBE - すぐそこに遺伝子（18/07/07） | 動画視聴はAbemaビデオ(AbemaTV)

体外受精や代理出産など不妊治療の技術が進むなか、いま実験段階の最新技術がある。それが「子宮移植」だ。今年5月、世界で初めて日本人医師らの研究グループが子宮移植を受けたサルの妊娠に成功。『AbemaNews』はその実験に独占密着した。
■生まれつき子宮がないAさん「選択できるということが救い」
「中学生の時に生理がなくて、子宮がない状態だとわかったのは17歳の時。病院を受診した時にわかりました」

今から10年ほど前、自分の体の異変に気が付いたというAさん(26)。17歳のAさんに宣告されたのは、生まれつき子宮がないという事実。病名は「ロキタンスキー症候群」で、先天的に子宮と膣の全部もしくは一部が欠けた状態で生まれてくる疾患だ。女児の4000人から5000人に1人の割合で起きるといわれている。
「診断名として聞くと頭は真っ白になっちゃうんですけど、自分よりも母親の顔を見るのがつらかったかな…」とAさん。「子宮がない」――娘の病気を知った母親は涙を流し「ごめんね」と謝ったという。
日本に子宮を原因とする不妊患者は、20代から30代だけでも約6~7万人いるといわれている。代理出産が認められていない日本で、ロキタンスキー症候群の患者は自分の子を持てないのが現状だ(養子縁組を除く)。
そんななか、驚くべき研究が進んでいる。滋賀医科大学動物生命科学研究センターで行われていたのは、サルからサルに子宮を移植する手術。この動物実験が、子宮が原因で妊娠することができない人に大きな可能性を秘めているという。

慶応義塾大学産婦人科の木須伊織医師が率いる慶応大学などの研究グループは、2009年から子宮移植の動物実験を開始した。実験の目的はヒトへの応用。サルの体重は3キロ前後と成人女性の20分の1程度しかないため、子宮も小さく手術はヒトの場合よりも難しいと考えられている。手術はヒトで行う子宮移植を想定して進められ、摘出された子宮は速やかに移植される。

日本における動物での子宮移植の技術は世界でも群を抜いており、この手術の様子を見ようと各国から医師が見学に訪れていた。「韓国でもいずれヒトでの子宮移植をやりたいと思っています。この動物実験にとても深い感銘を受けています」(韓国のソウミンジョン医師)、「手術手技はとても繊細で、出血もほとんどなく学ぶことが多いです」(中国の劉宇医師)。
そして、動物実験を始めて9年が経った今年5月、「来た来た来た来た!」「すごい心拍がしっかり!」「生きてるよ…ちゃんと」と医師たちから上がる歓声。ついに、世界で初めて子宮移植後のサルが妊娠したのだ。

子宮移植のプロセスは、まず事前に卵子を摘出し受精卵を凍結保存。ドナーからレシピエントに子宮を移植、子宮が定着し生理が再開されたのち、受精卵を子宮に戻す。妊娠し無事に出産した後は、再び子宮を摘出する。通常の臓器移植とは異なるが、出産後に再び子宮を摘出することで免疫抑制剤を飲み続けることを避けられるという。
子宮移植の対象となるのは、子宮頸がんなどの病気で子宮を摘出した人、そしてAさんのような先天的に子宮をもたないロキタンスキー症候群の患者だ。もし子宮移植が可能になれば、妊娠のチャンスがやってくる。
「子どもを持つという選択肢がそもそもない状態にいるから、実際にその治療を選択するかしないかは個人の価値観になると思うんですけど、選択できるっていうことがあるだけでだいぶ精神的には救いになるかな」(Aさん)
■保険外診療時の費用は2000万円とも
子宮移植の分野で世界に先駆ける国がスウェーデン。すでにヒトで13件の子宮移植が行われ、6人から8例の出産が報告されている。

木須医師は、「基礎研究では我々日本とスウェーデンが国際的にもリードしてきた。我々も実験を行ってきた中で、彼らと同じような技術の提供ができるのではないかと。一部の患者さんには『早くしてくれませんか』『年齢も限られてきています』という方もいらっしゃって、我々としてはもちろんなるべく早く臨床研究として日本でも実施したいと思っています」とコメント。日本でも子宮移植の技術はすでに蓄積されたという。

しかし、課題はまだまだ残されている。例えば費用面を見ると、スウェーデンは本人負担が実質ゼロの一方、日本は保険外診療となった場合に2000万円(不妊治療ではなく移植医療と判断されれば3割負担)がかかると想定されている。またドナーへの負担も大きく、臓器移植法による脳死患者からの臓器提供の項目に子宮が含まれていないため、肝臓移植などと同様に生きている人からの提供が現実的となっている。手術時間は7~8時間かかるとされ、移植を受けた患者は「子宮移植」「帝王切開」「子宮摘出」の3回の開腹が必要となる。

社会学者で東京工業大学准教授の西田亮介氏は、「患者本人がリスクを承知したうえで引き受けるのであれば、そのような選択を国も尊重して保険適用と認めるのがスウェーデン。自己決定に対する尊重の在り方、成熟した社会の有り様として感銘を受ける」と国の体制に言及。一方、日本の課題は倫理的、社会的な側面にあるとし、「日本は自己決定の尊重について乏しく、政治的にも及び腰になりがち。自己決定を積極的に尊重していく姿勢に転換していく時代ではないかと思う」と述べた。
(AbemaTV/『けやきヒルズ』より)